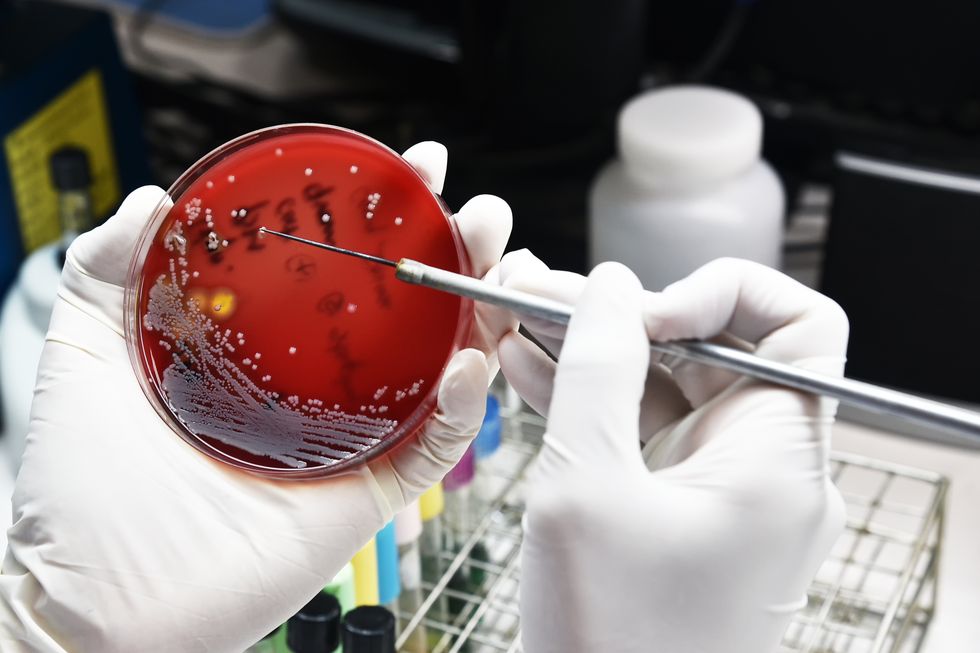

Drug resistant bacteria on petri dish (Shutterstock.com)
If it sometimes seems like the idea of antibiotic resistance, though unsettling, is more theoretical than real, please read on. Public health officials from Nevada are reporting on a case of a woman who died in Reno in September from an incurable infection. Testing showed the superbug that had spread throughout her system could fend off…



